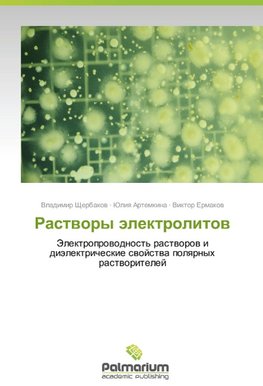
Rastwory älektrolitow

-
 Ruský jazyk
Ruský jazyk
Rastwory älektrolitow
Autor: Vladimir Shherbakow
Dlya opisaniya svoystv polyarnykh rastvoriteley ispol'zovana predel'naya vysokochastotnaya (VCh) elektroprovodnost' (EP), kotoraya predstavlyaet soboy otnoshenie absolyutnoy dielektricheskoy pronitsaemosti k vremeni dipol'noy dielektricheskoy relaksatsii.... Viac o knihe
Na objednávku
57.67 €
bežná cena: 60.70 €
O knihe
Dlya opisaniya svoystv polyarnykh rastvoriteley ispol'zovana predel'naya vysokochastotnaya (VCh) elektroprovodnost' (EP), kotoraya predstavlyaet soboy otnoshenie absolyutnoy dielektricheskoy pronitsaemosti k vremeni dipol'noy dielektricheskoy relaksatsii. Dlya vodnykh rastvorov neorganicheskikh soley vmesto pravila Val'dena predlozheno uravnenie, v kotorom konstanta imeet razmernost' kontsentratsii. Udel'naya EP kontsentrirovannykh vodnykh rastvorov neorganicheskikh soley sostavlyaet nekotoruyu dolyu ot predel'noy VCh EP vody. Predlozheny uravneniya, kotorye pozvolyayut otsenit' udel'nuyu EP kontsentrirovannykh vodnykh rastvorov na osnove koordinatsionnykh chisel ionov i dielektricheskikh svoystv rastvoritelya. Pri uvelichenii temperatury udel'naya EP rastvorov soley vozrastaet pryamo proportsional'no velichine predel'noy VCh EP rastvoritelya. Eta proportsional'nost' nablyudaetsya v vodnykh, nevodnykh i smeshannykh vodno-organicheskikh rastvoritelyakh i vypolnyaetsya v oblasti, gde EP rastvorov umen'shaetsya s rostom temperatury. Provedeno obobshchenie temperaturnoy i kontsentratsionnoy zavisimostey udel'noy EP rastvorov ionnykh zhidkostey, sil'nykh i slabykh elektrolitov.
- Vydavateľstvo: Palmarium Academic Publishing
- Rok vydania: 2012
- Formát: Paperback
- Rozmer: 220 x 150 mm
- Jazyk: Ruský jazyk
- ISBN: 9783847393566



 Nemecký jazyk
Nemecký jazyk 



 Anglický jazyk
Anglický jazyk 




